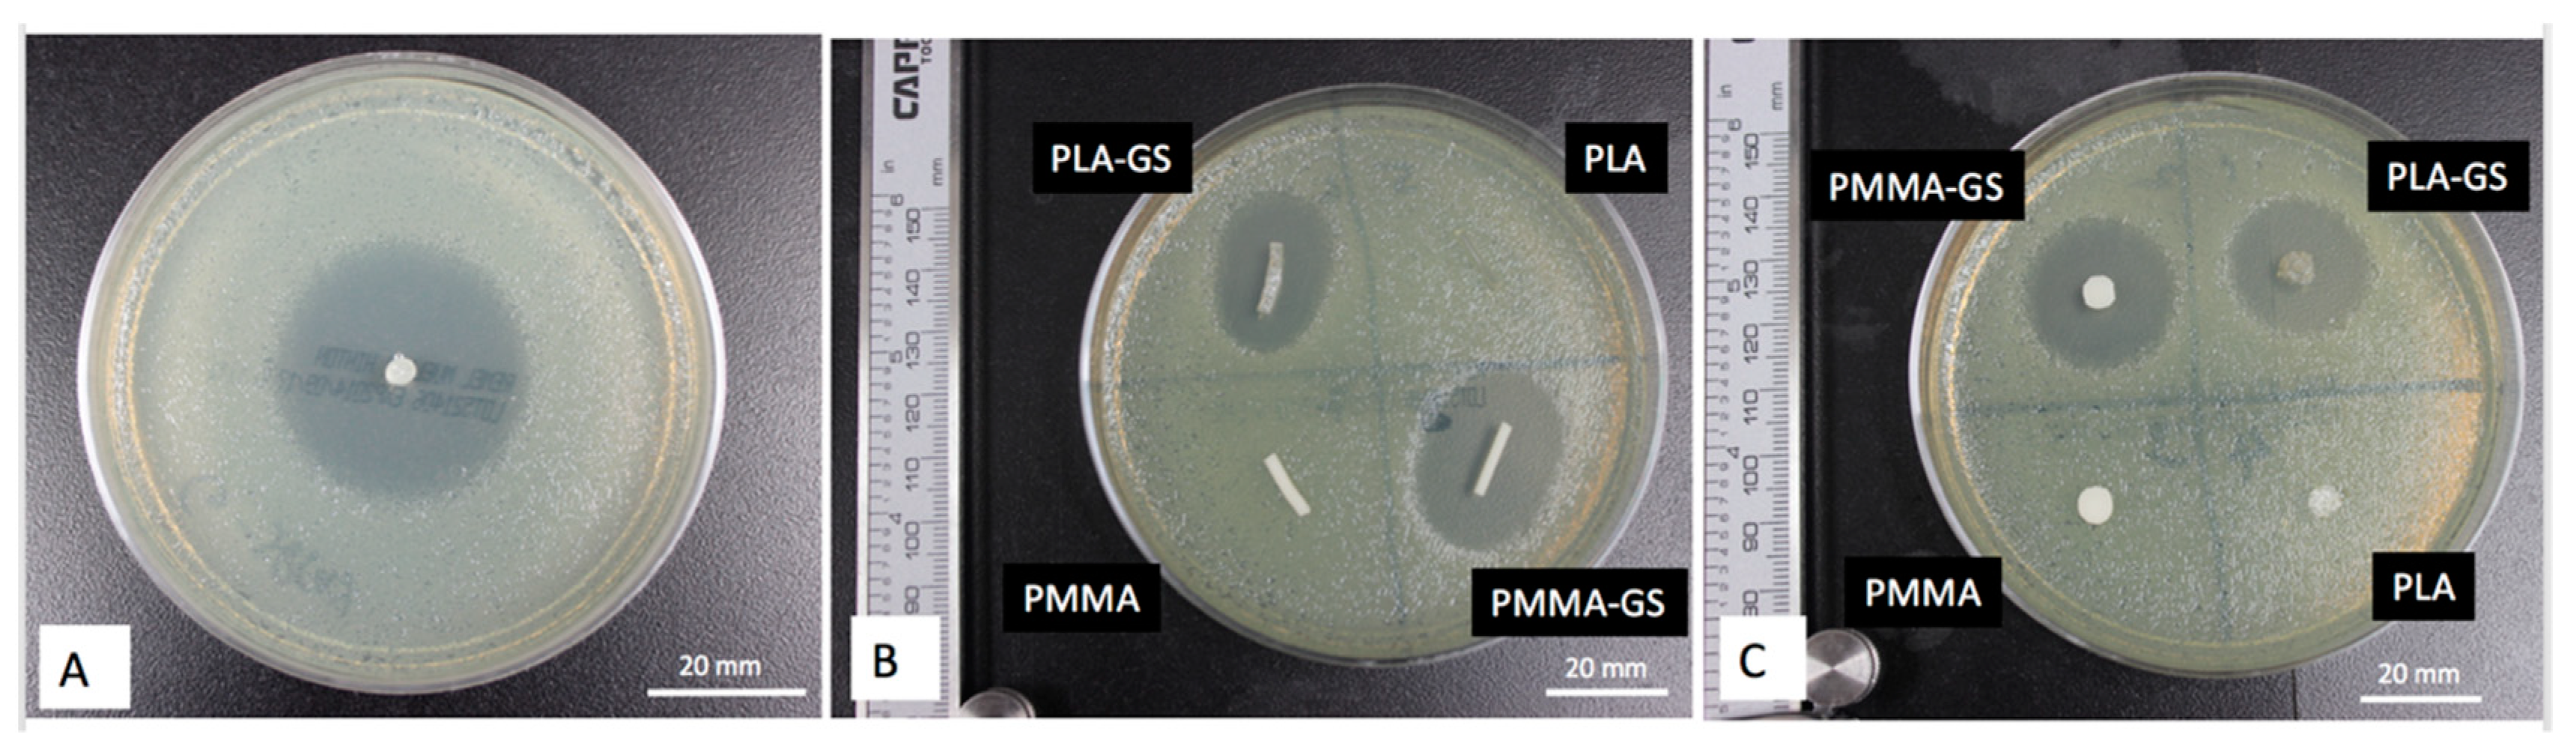
Jfb 10 00017 g010 Jfb 10 00017 g010

3D Printing Custom Bioactive and Absorbable Surgical Screws, Pins, and Bone Plates for Localized Drug Delivery
Abstract
1. Introduction
2. Materials and Methods
2.1. Materials
2.2. Methods
2.2.1. Fabricating Drug Loaded Scaffolds
2.2.2. Mechanical Evaluation
2.2.3. Antibacterial and Chemotherapeutic Properties
2.2.4. Statistical Analysis
3. Results
3.1. Mechanical Properties
3.2. Antibacterial and Chemotherapeutic Properties
4. Discussion
Author Contributions
Funding
Conflicts of Interest
References
- Saini, M. Implant biomaterials: A comprehensive review. World J. Clin. Cases 2015, 3, 52. [Google Scholar] [CrossRef] [PubMed]
- Havaldar, R.; Pilli, S.; Putti, B. Insights into the effects of tensile and compressive loadings on human femur bone. Adv. Biomed. Res. 2014, 3, 101. [Google Scholar] [CrossRef] [PubMed]
- Misch, C.E.; Qu, Z.; Bidez, M.W. Mechanical properties of trabecular bone in the human mandible: Implications for dental implant treatment planning and surgical placement. J. Oral Maxillofac. Surg. 1999, 57, 700–706. [Google Scholar] [CrossRef]
- Smeltzer, M.S.; Nelson, C.L.; Evans, R.P. Biofilms and Aseptic Loosening. In The Role of Biofilms in Device-Related Infections; Springer: Berlin/Heidelberg, Germany, 2008; pp. 57–74. [Google Scholar]
- Buchholz, H.W.; Engelbrecht, H. [Depot effects of various antibiotics mixed with Palacos resins]. Chirurg 1970, 41, 511–515. [Google Scholar]
- Mano, J.F.; Sousa, R.A.; Boesel, L.F.; Neves, N.M.; Reis, R.L. Bioinert, biodegradable and injectable polymeric matrix composites for hard tissue replacement: State of the art and recent developments. Compos. Sci. Technol. 2004, 64, 789–817. [Google Scholar] [CrossRef]
- Park, H.; Temenoff, J.S.; Mikos, A.G. Biodegradable Orthopedic Implants. In Engineering of Functional Skeletal Tissues; Springer: London, UK, 2007; pp. 55–68. [Google Scholar]
- Tappa, K.; Jammalamadaka, U.; Ballard, D.H.; Bruno, T.; Israel, M.R.; Vemula, H.; Meacham, J.M.; Mills, D.K.; Woodard, P.K.; Weisman, J.A. Medication eluting devices for the field of OBGYN (MEDOBGYN): 3D printed biodegradable hormone eluting constructs, a proof of concept study. PLoS ONE 2017, 12, e0182929. [Google Scholar] [CrossRef]
- Ballard, D.H.; Weisman, J.A.; Jammalamadaka, U.; Tappa, K.; Alexander, J.S.; Griffen, F.D. Three-dimensional printing of bioactive hernia meshes: In vitro proof of principle. Surgery 2017, 161, 1479–1481. [Google Scholar] [CrossRef] [PubMed]
- Ventola, C.L. Medical Applications for 3D Printing: Current and Projected Uses. P T 2014, 39, 704–711. [Google Scholar]
- Weisman, J.A.; Nicholson, J.C.; Tappa, K.; Jammalamadaka, U.; Wilson, C.G.; Mills, D.K. Antibiotic and chemotherapeutic enhanced three-dimensional printer filaments and constructs for biomedical applications. Int. J. Nanomed. 2015, 10, 357–370. [Google Scholar]
- Qu, G.-X.; Ying, Z.-M.; Zhao, C.-C.; Yan, S.-G.; Cai, X.-Z. Mechanical Properties and Porosity of Acrylic Cement Bone Loaded with Alendronate Powder. Int. J. Med. Sci 2018, 15, 1458–1465. [Google Scholar] [CrossRef]
- Nadernezhad, A.; Unal, S.; Khani, N.; Koc, B. Material extrusion-based additive manufacturing of structurally controlled poly(lactic acid)/carbon nanotube nanocomposites. Int. J. Adv. Manuf. Technol. 2019, 1–14. [Google Scholar] [CrossRef]
- Sheikh, Z.; Najeeb, S.; Khurshid, Z.; Verma, V.; Rashid, H.; Glogauer, M.; Sheikh, Z.; Najeeb, S.; Khurshid, Z.; Verma, V.; et al. Biodegradable Materials for Bone Repair and Tissue Engineering applications. Materials 2015, 8, 5744–5794. [Google Scholar] [CrossRef] [PubMed]
- Weisman, J.A.; Ballard, D.H.; Jammalamadaka, U.; Tappa, K.; Sumerel, J.; D’Agostino, H.B.; Mills, D.K.; Woodard, P.K. 3D Printed Antibiotic and Chemotherapeutic Eluting Catheters for Potential Use in Interventional Radiology. Acad. Radiol. 2018, 26, 270–274. [Google Scholar] [CrossRef] [PubMed]
- Ballard, D.H.; Jammalamadaka, U.; Tappa, K.; Weisman, J.A.; Boyer, C.J.; Alexander, J.S.; Woodard, P.K. 3D printing of surgical hernia meshes impregnated with contrast agents: In vitro proof of concept with imaging characteristics on computed tomography. 3D Print. Med. 2018, 4, 13. [Google Scholar] [CrossRef] [PubMed]
- Boyer, C.J.; Ballard, D.H.; Weisman, J.A.; Hurst, S.; McGee, D.J.; Mills, D.K.; Woerner, J.E.; Jammalamadaka, U.; Tappa, K.; Alexander, J.S. Three-Dimensional Printing Antimicrobial and Radiopaque Constructs. 3D Print. Addit. Manuf. 2018, 5. [Google Scholar] [CrossRef]
- Boyer, C.J.; Boktor, M.; Samant, H.; White, L.A.; Wang, Y.; Ballard, D.H.; Huebert, R.C.; Woerner, J.E.; Ghali, G.E.; Alexander, J.S.; et al. 3D Printing for Bio-Synthetic Biliary Stents. Bioengineering 2019, 6, 16. [Google Scholar] [CrossRef] [PubMed]
- Ballard, D.H.; Trace, A.P.; Ali, S.; Hodgdon, T.; Zygmont, M.E.; DeBenedectis, C.M.; Smith, S.E.; Richardson, M.L.; Patel, M.J.; Decker, S.J.; et al. Clinical Applications of 3D Printing: Primer for Radiologists. Acad. Radiol. 2018, 25, 52–65. [Google Scholar] [CrossRef] [PubMed]
- Kargozar, S.; Montazerian, M.; Hamzehlou, S.; Kim, H.-W.; Baino, F. Mesoporous bioactive glasses: Promising platforms for antibacterial strategies. Acta Biomater. 2018, 81, 1–19. [Google Scholar] [CrossRef] [PubMed]
- Prasad, K.; Bazaka, O.; Chua, M.; Rochford, M.; Fedrick, L.; Spoor, J.; Symes, R.; Tieppo, M.; Collins, C.; Cao, A.; et al. Metallic Biomaterials: Current Challenges and Opportunities. Materials 2017, 10, 884. [Google Scholar] [CrossRef] [PubMed]
- Calhoun, J.H.; Mader, J.T. Antibiotic beads in the management of surgical infections. Am. J. Surg. 1989, 157, 443–449. [Google Scholar] [CrossRef]
- Di Prima, M.; Coburn, J.; Hwang, D.; Kelly, J.; Khairuzzaman, A.; Ricles, L. Additively manufactured medical products—The FDA perspective. 3D Print. Med. 2016, 2, 1. [Google Scholar] [CrossRef] [PubMed]
- Ricles, L.M.; Coburn, J.C.; Di Prima, M.; Oh, S.S. Regulating 3D-printed medical products. Sci. Transl. Med. 2018, 10, eaan6521. [Google Scholar] [CrossRef] [PubMed]
- Chepelev, L.; Wake, N.; Ryan, J.; Althobaity, W.; Gupta, A.; Arribas, E.; Santiago, L.; Ballard, D.H.; Wang, K.C.; Weadock, W.; et al. Radiological Society of North America (RSNA) 3D printing Special Interest Group (SIG): Guidelines for medical 3D printing and appropriateness for clinical scenarios. 3D Print. Med. 2018, 4, 11. [Google Scholar] [CrossRef] [PubMed]
- New ACR-Sponsored CPT Codes Approved by the AMA | American College of Radiology. Available online: https://www.acr.org/Advocacy-and-Economics/Advocacy-News/Advocacy-News-Issues/In-the-November-2-2018-Issue/New-ACR-Sponsored-CPT-Codes-Approved-by-the-AMA (accessed on 14 February 2019).

© 2019 by the authors. Licensee MDPI, Basel, Switzerland. This article is an open access article distributed under the terms and conditions of the Creative Commons Attribution (CC BY) license (http://creativecommons.org/licenses/by/4.0/).
Share and Cite
Tappa, K.; Jammalamadaka, U.; Weisman, J.A.; Ballard, D.H.; Wolford, D.D.; Pascual-Garrido, C.; Wolford, L.M.; Woodard, P.K.; Mills, D.K. 3D Printing Custom Bioactive and Absorbable Surgical Screws, Pins, and Bone Plates for Localized Drug Delivery. J. Funct. Biomater. 2019, 10, 17. https://doi.org/10.3390/jfb10020017
Tappa K, Jammalamadaka U, Weisman JA, Ballard DH, Wolford DD, Pascual-Garrido C, Wolford LM, Woodard PK, Mills DK. 3D Printing Custom Bioactive and Absorbable Surgical Screws, Pins, and Bone Plates for Localized Drug Delivery. Journal of Functional Biomaterials. 2019; 10(2):17. https://doi.org/10.3390/jfb10020017
Chicago/Turabian StyleTappa, Karthik, Udayabhanu Jammalamadaka, Jeffery A. Weisman, David H. Ballard, Dallas D. Wolford, Cecilia Pascual-Garrido, Larry M. Wolford, Pamela K. Woodard, and David K. Mills. 2019. "3D Printing Custom Bioactive and Absorbable Surgical Screws, Pins, and Bone Plates for Localized Drug Delivery" Journal of Functional Biomaterials 10, no. 2: 17. https://doi.org/10.3390/jfb10020017
APA StyleTappa, K., Jammalamadaka, U., Weisman, J. A., Ballard, D. H., Wolford, D. D., Pascual-Garrido, C., Wolford, L. M., Woodard, P. K., & Mills, D. K. (2019). 3D Printing Custom Bioactive and Absorbable Surgical Screws, Pins, and Bone Plates for Localized Drug Delivery. Journal of Functional Biomaterials, 10(2), 17. https://doi.org/10.3390/jfb10020017

